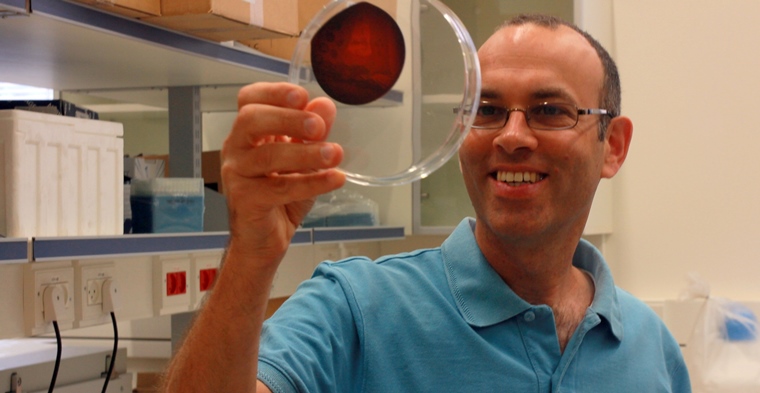

Créditos de las imagenes: Technion press room.
Antibióticos a medida. Una tecnología innovadora desarrollada por investigadores de Israel puede mejorar y hacer más eficiente el tratamiento con antibióticos.
La tecnología también dificultará el desarrollo de bacterias resistentes. El estudio fue publicado en Nature Medicine, y se hizo posible gracias a una colaboración única entre el Instituto KSM de Maccabi, dirigido por la profesora Varda Shalev, y los investigadores del Technion, el profesor Roy Kishony y el Doctor Idan Yelin.
El uso de antibióticos a nivel mundial es extenso y lleva a que las bacterias desarrollen resistencia. Como resultado, los antibióticos pierden su efectividad. Esto genera la preocupación de que, en el futuro, las infecciones bacterianas se volverán refractarias a los antibióticos.
Las infecciones que ahora se consideran leves y no peligrosas se volverán resistentes al tratamiento y serán mortales.
Antibióticos a medida o resistencia a los antibióticos.
Uno de los factores que acelera la evolución de la resistencia a los antibióticos es el uso generalizado de antibióticos de amplio alcance. Se trata de medicamentos diseñados para matar un amplio espectro de bacterias.
La reducción de esta tendencia peligrosa puede lograrse mediante la prescripción de antibióticos dirigidos específicamente a las bacterias causantes de infección. Antibióticos a medida para cada paciente en particular.
El profesor Roy Kishony, uno de los principales expertos en el campo de la resistencia a los antibióticos, desarrolló métodos para el mapeo genético de la resistencia bacteriana a los antibióticos.
Estas técnicas permiten predecir la resistencia de una bacteria dada a varios antibióticos en el presente e incluso al nivel de resistencia que las bacterias pueden desarrollar en el futuro.
El estudio actual se centró en un tipo específico de infección, en el tracto urinario, que afecta a más de la mitad de las mujeres en algún momento de sus vidas.
Estas infecciones involucran diversas bacterias, entre ellas Klebsiella pneumoniae, E. coli y Proteus mirabilis.
En el estudio conjunto realizado por el Technion y Maccabi, se desarrolló un sistema para ayudar al médico a elegir el antibiótico óptimo para tratar las infecciones del tracto urinario.
Los investigadores encontraron que los niveles de resistencia a los antibióticos eran diferentes para cada paciente. Ademas un cierto antibiótico será efectivo en un paciente y no en otro.
Las razones de esto están relacionadas con las características personales y el historial médico de cada paciente.
Antibióticos a medida.
«Ahora es posible predecir computacionalmente el nivel de resistencia bacteriana para las bacterias causantes de infecciones», dijo el Dr. Yelin.
«Esto se hace ponderando datos demográficos, incluidos la edad, sexo, el embarazo o la residencia en la casa de retiro, junto con los niveles de resistencia medidos en los cultivos de orina anteriores del paciente. También se considera su historial de compra de medicamentos».
El estudio es un paso significativo en el campo innovador de los estudios médicos basados en aprendizaje automático y Big Data.
«La colaboración entre Maccabi y el Technion, uno de los institutos de investigación más innovadores del mundo, y la combinación de un profundo conocimiento de la medicina, Big Data y métodos de investigación innovadores han permitido un gran avance en el campo de la resistencia a los antibióticos», dijo el profesor Shalev.
«Esperamos que continúe la cooperación fructífera con el Technion y el Prof. Roy Kishony».
El estudio analizó más de cinco millones de casos de compras de antibióticos realizadas durante más de 10 años. Junto a esto, mediciones de resistencia a los antibióticos en más de 700,000 cultivos de orina.
Un sofisticado algoritmo pudo encontrar un vínculo claro entre los diversos datos y, por lo tanto, predecir el nivel de resistencia a los antibióticos para cada infección y brindar una recomendación sobre el mejor tipo de antibióticos.
El futuro de crear antibióticos a medida.
Los investigadores encontraron que el uso de la tecnología podría reducir la probabilidad de elegir la medicación incorrecta en aproximadamente un 40%.
Por lo tanto, estiman que este sistema contribuirá en gran medida al esfuerzo global para retrasar la «epidemia de resistencia».
La profesora Varda Shalev, es profesora de medicina en la Universidad de Tel Aviv y directora del Instituto de Investigación e Innovación KSM.
El Instituto se basa en el conocimiento profesional de los mejores investigadores y en la base de datos única de Maccabi. Desde su creación, se han realizado cientos de estudios que han contribuido a mejoras de gran alcance en el tratamiento médico proporcionado a la comunidad.
El Instituto estudia la base de datos de Maccabi, que incluye cientos de millones de visitas médicas, varios tipos de muestras de laboratorio y otros datos médicos. Mantiene una cooperación a largo plazo con investigadores del Technion, con el objetivo de desarrollar nuevas formas de analizar los datos médicos y su aplicación al bienestar de los pacientes.
Quieres conocer mas tecnología israelí?
Si respondiste “si” Sumanos también en Twitter.

FELICITACIONES POR LA INVESTIGACIÓN PREVENTIVA, AUNQUE EN ESTE CASO YA EXISTE LA RESISTENCIA A DIVERSOS ANTIBIÓTICOS Y EN DETERMINADOS PACIENTES.